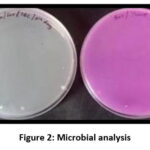

Development and Quality Evaluation of Baked Nutri Sev Incorporated with Jackfruit Seed Flour (Artocarpus heterophyllus) –an Edible Waste
Department of Home Science-Food Science Nutrition And Dietetics., Shrimathi Devkunvar Nanalal Bhatt Vaishnav College For Women, Chennai, India.
Corresponding Author E-mail:rajapraveena228@gmail.com
DOI : http://dx.doi.org/10.13005/bbra/3506
ABSTRACT:Sev, a conventional Indian snack from chickpea (Cicer arietinum) flour, spices, and oil-frying, was innovated here as a baked, nutrient-dense variant with chickpea and jackfruit seed (Artocarpusheterophyllus) flours. Eight formulations were tested with varying proportions of these flours. Sensory evaluation using a nine-point hedonic scale by 25 untrained members showed formulation T2 (70:30; chickpea flour: jackfruit seed flour) received the highest score and was selected for analysis.Physical properties of the optimized baked nutrisev (T2) including weight, thickness, width, pH, texture, and colour were evaluated. Functional properties of both flours were determined for bulk density, water and oil absorption, foam capacity, and stability. The proximate composition showed moisture (4.2%), ash (2.8%), energy (217.8 kcal), carbohydrate (17.1 g), protein (25.1 g), fat (2.4 g), fibre (3.25 g), calcium (381.16 mg), phosphorus (202 mg), and iron (5.07 mg).Microbial analysis showed no yeast or mould growth, with a bacterial count of 5 × 10⁴ CFU/g. Antioxidant activity was approximately 71%, with total phenolic and flavonoid contents of 0.078 mg/g and 0.50 mg/g. Shelf-life evaluation was conducted over 45 days, comparing storage in LDPE and airtight containers. Cost analysis showed the baked nutrisev (₹17) was more economical than conventional deep-fried sev (₹20), providing a cost-effective, nutrient-dense, healthier alternative to traditional fried snacks.
KEYWORDS:Chickpea flour; Jackfruit seed flour; Proximate analysis; Sensory analysis; Sev
Introduction
Sev is one of the most popular traditional Indian snacks, consisting of small, crispy noodle-like strands prepared from chickpea (Cicer arietinum) flour paste, seasoned with turmeric and chili powder, and deep-fried in oil.1,2 These noodles are available in various thicknesses and are widely consumed across the country. However, despite their palatability, conventional sev products are high in lipids due to the deep-frying process.15 Consequently, several studies have focused on reducing the oil content in such products to develop healthier alternatives.14 Jackfruit (Artocarpusheterophyllus) seeds, which are rich in protein, fibre, and carbohydrates, also contain essential minerals such as nitrogen (N), phosphorus (P), potassium (K), calcium (Ca), magnesium (Mg), sulfur (S), zinc (Zn), and copper (Cu) .11 Therefore, incorporating a blend of chickpea and jackfruit seed flour in the formulation of baked sev can provide a cost-effective, nutrient-enriched, and healthier snack alternative to the population.
Materials and Methods
Preparation of Control Sev
The control sev was prepared from a soft dough consisting of chickpea (Cicer arietinum) flour and spices, including oil, turmeric powder, asafoetida, and ajwain. The dough was extruded manually using a hand extruder and deep-fried in vegetable oil for 45–50 seconds, with intermittent turning to ensure uniform frying.
Preparation of Baked Nutri Sev
The product was prepared traditionally without the use of baking powder or any chemical preservatives. The baked nutrisev was developed following the method described by 9 with slight modifications. The preparation process involved two main stages: dough preparation and baking.
The dough was prepared by kneading chickpea (Cicer arietinum) flour and jackfruit seed (Artocarpusheterophyllus) flour with oil, ajwain water, salt, turmeric powder, mint extract, and water. In the control formulation, sev was prepared using 100% chickpea flour along with the above mentioned spices. In the experimental formulations, jackfruit seed flour was incorporated in varying proportions to evaluate its effect on the product characteristics represented in table 1.
Table 1: Treatment Table
| Sample | Chickpea Flour | Jackfruit Seed Flour |
| T0 | 100 | – |
| T1 | 80 | 20 |
| T2 | 70 | 30 |
| T3 | 60 | 40 |
| T4 | 50 | 50 |
| T5 | 40 | 60 |
| T6 | 30 | 70 |
| T7 | 20 | 80 |
All ingredients were accurately weighed using a digital weighing balance and mixed thoroughly to form a soft dough, which was allowed to rest for 10 minutes. The dough was then loaded into a hand extruder and extruded directly onto a greased baking tray. The extruded strands were baked in a microwave oven at an optimized temperature until a crispy texture was obtained. The baked sev was subsequently cooled to room temperature and stored in airtight containers to maintain its quality and prevent moisture absorption.
Sensory Evaluation of Sev
A sensory assessment of the formulated sev samples was conducted using the nine-point hedonic scale to measure the degree of liking and overall acceptability.20 Twenty-five untrained panellists participated in the evaluation.21 The panellists evaluated the sev samples based on five sensory parameters: appearance, texture, taste, flavour, and overall acceptability.20 The resulting scores were recorded andstatistically analysed to determine the most preferred formulation.21
Physicochemical Analysis
Physical Analysis
The physical properties of the sev samples were determined using standard analytical procedures. The thickness, length, and width of the sev were measured using a vernier caliper. Sample weight was determined using an electronic balance with an accuracy of ±0.0001 g. The pH of the samples was measured using a calibrated digital pH meter. Colour analysis was performed using a Hunter Lab colorimeter to obtain L, a, and b values. Texture profile analysis was carried out using a texture analyzer. To evaluate the hardness and crispiness of the baked sev samples.
Functional Characteristics of the Flours
The functional properties of the flours, including bulk density, water and oil absorption capacities, foam capacity, and stability, were analyzed.12,18
Chemical Analysis
Chemical composition, including moisture, ash, fat, crude fiber, carbohydrate, and protein, was determined using standard AOAC (2002) methods. Mineral contents, such as calcium, iron, and phosphorus, were also analyzed.
Microbial Analysis
Microbial analyses were performed using the Total Plate Count (TPC) method and the spread plate technique to enumerate yeast and mold populations, following standard microbiological procedures.13
Antioxidant Analysis of the Sev
Jackfruit seed flour is rich in antioxidants and the antioxidant capacity was measured. Total phenolic content, total flavonoid content and the DPPH Scavenging capacity were analyzed.
Shelf Life Analysis of the Sev
Shelf life refers to the ability of a food product to maintain its sensory, physicochemical, textural, functional, and microbiological quality over a defined storage period without undergoing significant deterioration.10
Sensory Characteristics of the Baked Nutri Sev stored in different packaging
The shelf life of the baked nutrisev was evaluated by storing the product in Low-Density Polyethylene (LDPE) and airtight containers for a period of 45 days. Sensory evaluation was conducted on the 0th, 15th, 30th, and 45th day of storage to assess changes in acceptability over time.
Microbial Analysis of the Baked Nutri Sev during the Shelf life period
Microbial analysis of the baked nutrisev (T2) was conducted on the 0th, 15th, 30th, and 45th day of storage. Lower microbial growth was considered indicative of better product stability and a longer shelf-life.
Cost Analysis of the Sev
The cost analysis included food ingredient cost, labour cost, overhead charges, and indirect expenses. The price per kilogram of sev was computed using the cost estimation method described by.8
Cost of production (per kilogram) = Cost A + Cost B/ Q
Cost A – Cost of raw materials, Cost B – Cost of processing, Q – Quantity of sev obtained (kg)
Results
Sensory evaluation was conducted using a nine-point hedonic scale with 25 untrained panelists. Samples from the control (T0) to the treatment formulations (T1–T7) were assessed. Among these, Treatment T2 (70:30 ratio of chickpea flour to jackfruit seed flour) received the highest acceptability scores (Table 2).
Table 2: Sensory Characteristics
| Parameters | T0 | T1 | T2 | T3 | T4 | T5 | T6 | T7 |
| Colour | 8.24±
0.72 |
8.2±
0.95 |
8.12±
0.72 |
7.28±
0.93 |
7.16±
1.106 |
6.96±
1.135 |
6.32±
0.945 |
6.12±
1.268 |
| Texture | 8.4±0.76 | 8.36±
0.75 |
8.44±
0.58 |
7.52±
0.91 |
7.36±
0.99 |
7.16±
1.14 |
6.72±
1.021 |
6.36±
1.41 |
| Appearance | 8.52±0.65 | 8.4±
0.707 |
8.48±
0.58 |
7.64±
0.907 |
7.48±
1.00 |
7.28±
1.17 |
6.76±
1.09 |
6.52±
1.475 |
| Taste/Flavor | 8.64±
0.56 |
8.4±
0.76 |
8.52±
0.50 |
7.64±
0.90 |
7.4±
1.040 |
7.24±
1.12 |
6.88±
1.16 |
6.48±
1.41 |
| Overall
Acceptability |
8.68±
0.55 |
8.52±
0.65 |
8.72±
0.45 |
7.8±
0.76 |
7.6±
1.045 |
7.48±
1.04 |
7.24±
1.04 |
6.92±
1.164 |
Physical Analysis
The physical characteristics of the control and baked nutrisev were evaluated to determine structural and textural differences. The weight of the samples was measured using an electronic balance, while the width and thickness were recorded using a vernier caliper. The thickness of the strands varied depending on the hand extruder used. The pH values of the samples were determined in triplicates, and the mean are presented in Table 3.
Table 3: Physical Analysis
| Parameter | Control sev(T0) | Baked nutrisev(T2) |
| Width(mm) | 4.66 ± 0.057 | 4.56 ± 0.57 |
| Thickness(mm) | 0.56 ±0.057 | 0.46 ± 0.057 |
| pH | 5.633±0.321 | 5.833±0.152 |
| Texture(hardness) | 1667 | 1298.372 |
| L* | 43±1 | 53±1 |
| a* | 6.1±0.1 | 7.97±0.5 |
| b* | 10.7±0.6 | 23.3±1.16 |
Texture profile analysis was conducted using a Texture Analyzer (TA.XT Plus). Consistent with earlier findings 9 the control sev exhibited higher hardness compared to the baked nutrisev. For the optimized baked formulation (T2), the textural parameters obtained were: fracturability (1412.56 g), adhesiveness (0.026), springiness (0.239), cohesiveness (0.049), gumminess (261.73), chewiness (80.05), and resilience (0.21), indicating a crisp yet soft-breaking texture desirable for snack products.
Colour measurements (L*, a*, and b*) in table 3 showed increased b* values, mainly due to the presence of turmeric and the effect of baking duration. Variations in colour among samples were attributed to differences in baking time, temperature, and the incorporation level of jackfruit seed flour, which influenced the final appearance of the sev 9
Functional Characteristics of the flour
The functional properties of chickpea flour and jackfruit seed flour were evaluated and presented in Table 4 & figure 1. The bulk density of jackfruit seed flour (0.80 ± 0.35 g/cm³) was higher than that of chickpea flour (0.459 ± 0.04 g/cm³), indicating greater particle compactness, which may be beneficial in formulations requiring higher solid content (Narayana &Narasinga Rao, 1984). Chickpea flour exhibited a higher water absorption capacity (130.9 ± 60%) compared to jackfruit seed flour (112.00 ± 0.20%), suggesting the presence of more hydrophilic constituents and better suitability for dough systems requiring moisture retention.18 Conversely, jackfruit seed flour demonstrated superior oil absorption capacity (126.00 ± 0.50%) than chickpea flour (108.8 ± 1.30%), which may enhance flavor retention and mouthfeel in fat-rich preparations. Chickpea flour also showed higher foam capacity (45.3 ± 2.10%) and foam stability (40.01 ± 1.70%) than jackfruit seed flour (25.34 ± 0.30% and 33.00 ± 0.60%, respectively), indicating better performance in aerated food products such as batters and baked goods. Overall, the variations in functional properties reflect inherent compositional and structural differences between the two flours, influencing their potential applications in food product development.
Table 4: Functional Characteristics Of Flours
| Materials/Parameters | Chickpea Flour | Jackfruit Seed Flour |
| Bulk Density (gm/cm3) | 0.459 ± 0.04 | 0.80 ± 0.35 |
| Water absorption capacity (%) | 130.9 ± 60 | 112.00 ± 0.20 |
| oil absorption capacity (%) | 108.8 ± 1.30 | 126.00 ± 0.50 |
| Foam capacity (%) | 45.3 ± 2.10 | 25.34 ± 0.30 |
| Foam stability (%) | 40.01 ± 1.70 | 33.00 ± 0.60 |
![]() |
Figure 1: Water and Oil absorption capacity
|
Chemical Analysis
The chemical composition of the sev samples was analyzed, and the results are summarised in Table 5. The overall energy value of treatment T2 was 217.84 kcal, which was considerably lower than the control sev (521.10 kcal). A similar study reported an energy value of 433 kcal for baked sev prepared using chickpea, horsegram, and rice flours.9 The reduced energy content in T2 is mainly attributed to the lower carbohydrate and fat levels. The carbohydrate content of the control sev was 46 g, whereas treatment T2 contained only 17 g. This reduction was influenced by the incorporation of jackfruit seed flour, which is naturally lower in carbohydrates. The combination of jackfruit seed flour with chickpea flour also resulted in a protein-enriched product. Treatment T2 had a protein content of 25 g, compared to 15 g in the control sev, aligning with reports that jackfruit seed flour contributes a diverse range of essential and non-essential amino acids.7
Table 5: Chemical Analysis
| Parameters | Control Sev (T0) | Baked Nutri Sev (T2) |
| Moisture (%) | 5.23 ± 0.20 | 4.225 ± 0.23 |
| Ash (%) | 1.2 ± 0.26 | 2.86 ± 0.31 |
| Energy (kcal) | 521.1 ± 0.95 | 217.84 ± 1.59 |
| Protein(g) | 15.43 ±0.48 | 25.16 ± 0.28 |
| Fat(g) | 30.16 ± 0.05 | 2.49 ± 0.07 |
| Carbohydrate(g) | 46.49 ± 0.090 | 17.122 ± 0.105 |
| Fibre(g) | 0.54 ± 0.05 | 3.25 ± 0.13 |
| Iron (mg) | 2.0 ± 0.05 | 5.07 ± 0.02 |
| Calcium (mg) | 191.61 ± 0.06 | 381.16 ± 0.14 |
| Phosphorus (mg) | 310 ± 0.05 | 202 ± 0.020 |
The fat content of treatment T2 was also lower than that of the control. This difference was due to the method of preparation: the control sev was deep-fried and prepared entirely from chickpea flour, which has higher oil absorption capacity, whereas treatment T2 was baked, requiring minimal oil. Dietary fibre content was markedly improved in T2 (3.25 g) compared to the control (0.54 g), and was also higher than previously reported fibre values (0.85 g) in baked sevformulations containing horsegram and rice flour.9
Moisture content was lower in treatment T2 than in the control sev, due to microwave drying of jackfruit seed flour prior to incorporation. As reported by 2, a decrease in moisture content is generally accompanied by an increase in ash concentration; however, only slight variation in ash content was observed between the samples. The iron content was higher in treatment T2 (5 mg) compared to the control sev (2 mg), which is consistent with the naturally high iron concentration of jackfruit seeds (18 mg/100 g) .3 Calcium levels were also higher in the jackfruit seed flour based sev, while phosphorus content was lower, likely due to mineral loss during processing.
Microbial Analysis
Microbial analysis was performed to determine the total bacterial load and the yeast and mould counts of the baked Nutri Sev, and the results are presented in Table 6.
Table 6: Microbial Analysis
| Parameters | Method | Units | Results |
| Total Bacterial Count | IS 54402: 2012 (RA.2018) | CFU/g | 5*104 |
| Yeast Andmould Count | IS 5403: 1999 (RA.2013) | CFU/g | – |
![]() |
Figure 2: Microbial analysis
|
The total bacterial count was recorded as 5 × 10⁴ CFU/g, while no yeast or mould growth was detected throughout the analysis period (Fig 5). The microbial load of the product fell within the acceptable limits recommended by the International Commission on Microbiological Specifications for Foods (ICMSF), which specifies a maximum limit of 10⁵ CFU/g for ready-to-eat food products.1
Antioxidant Analysis of the Sev
The antioxidant activity of the baked Nutri Sev (T2) was assessed, and the results are presented in Table 7. The baked nutrisev exhibited a total phenolic content of 0.078 mg/g. Earlier studies reported that methanolic extracts of jackfruit seeds showed phenolic contents of 1.45 g GAE/mg extract and 2.12 g GAE/mg extract, depending on the solvent system used .5 The variation in phenolic content may be attributed to differences in solvent polarity and extraction efficiency, as well as temperature and processing duration, which are known to influence phenolic stability.6
Table 7: Antioxidant Analysis
| S.No | Particular | Values |
| 1 | Total phenols (mg/g) | 0.078 |
| 2 | Total flavonoid mg/ g | 0.50 |
| 3 | Scavenging % | 71.85 |
![]() |
Figure 3: Total phenolic, totalflavonoid and DPPH Scavenging
|
The total flavonoid content of the baked nutrisev was 0.50 mg/g. In comparison, acetoneand dichloromethane extracts of jackfruit seed methanolic extract were reported to contain 290 g/mg and 457 g/mg of flavonoids, respectively 5 , while acetone extracts were shown to have 0.61 mg CE/g 17, These differences may be due to variation in extraction solvents and estimation methods, which significantly affect flavonoid yield .16
The DPPH free radical scavenging activity of the baked nutrisev was 71.85%, which falls within the previously reported range of 49.0–72.14% for jackfruit seeds. The antioxidant capacity decreases with longer processing time, higher temperature, and increasing ethanol concentration during extraction.6
Shelf Life Analysis of the Sev
The shelf life evaluation showed that the baked nutrisev maintained acceptable sensory characteristics throughout storage. Sensory scores for appearance, texture, taste, flavour, and overall acceptability were highest on the 0th and 15th days, with a slight decline observed on the 30th and 45th days in figure 4a, 4b. Products stored in an airtight container in figure 5a, 5b retained better sensory quality compared to those stored in LDPE packaging, as indicated by reduced changes in colour, texture, and crispness by the end of the storage period.Previous research supports this finding, showing that aluminum laminate packaging, due to its lower oxygen transmission rate, preserves sev quality better than LDPE and polypropylene, maintaining acceptability for up to 75 days. 9
Table 8: Shelf Life Analysis
| Days | Bacterial×104 Cfucount | Yeast Count
Or Mold |
| 1ST DAY | 1 | 0 |
| 15TH DAY | 2 | 0 |
| 30TH DAY | 3 | 0 |
| 45TH DAY | 6 | 0 |
![]() |
Figure 4: (a, b). Shelf-life analysis of the baked nutrisev stored in LDPE
|
![]() |
Figure 5: (a, b). Shelf-life analysis of the baked nutrisev stored in Airtightcontainer
|
Microbial analysis
Microbial analysis was conducted on the 0th, 15th, 30th and 45th days of storage. No yeast or mold growth was detected throughout the storage period, which may be attributed to the low moisture content of the baked nutrisev. The total bacterial count increased gradually from 1×10⁴ CFU/g on the 0th day to 6×10⁴ CFU/g by the 45th day. A similar trend of slight microbial increase during extended storage has been reported in baked snack products 19 Importantly, the microbial load remained within the acceptable limit of 10⁵ CFU/g for ready-to-eat foods, as recommended by the International Commission on Microbiological Specifications for Foods (ICMSF) 1 Therefore, the product was considered microbiologically safe for consumption up to 45 days.
![]() |
Figure 6: Microbial analysis during the shelf-life period
|
Cost analysis of the sev
The cost of the sev (per kg ) was estimated through the following formula
Cost of production (per kilogram) = Cost A + Cost B/ Q
Cost A – Cost of raw materials, Cost B – Cost of processing, Q – Quantity of sev obtained (kg)
The cost of production was systematically evaluated. The total production cost for 100 g of baked nutrisev was calculated to be ₹17, whereas the cost of commercially available sev of equivalent weight was ₹20. This indicates that the formulated baked nutrisev is economically more affordable compared to the commercial product. Moreover, the baked nutrisev offers improved nutritional quality, characterized by higher protein, higher dietary fibre, lower fat, and enhanced micronutrient content due to the incorporation of jackfruit seed flour. Therefore, the baked nutrisev can be considered a nutrient-dense and cost-effective snack alternative, making it suitable for wider consumer acceptance and potential commercialization.
Table 9: Cost Calculation
| Particulars | Cost/100g |
| Control Sev T0 | RS. 20 |
| Baked Nutri Sev T2 | RS. 17 |
Discussion
Physical analysis
Treatment T2 (70:30 chickpea to jackfruit seed flour) emerged as the most accepted one, with optimal blend of traditional palatability along with nutritional upgrade. A desirable crisp yet soft breaking texture was attained in the baked nutrisev. Reduction in hardness from the traditional deep-fried sev(control) is an important improvement from the sensory perspective. An increase in the b* values, representing the yellowness component, is attributed to the addition of turmeric, followed by baking. Finally, the overall color depends on the baking temperature and the proportion of jackfruit seed flour addition.
Functional characteristics
The bulk density of jackfruit seed flour was higher (0.80 g/cm³) compared with chickpeas, enabling a dense product with a higher nutritional content.Higher water absorption capacity (130.9%) in chickpea flour ensures that it is suitable for preparing the dough.High oil absorptive capacity (126.00%) in jackfruit seed flour could be an important consideration in a baked food with low total fat content.The increased foam capacity supplied by the chickpea flour indicates that the major role of providing aeration to the sev is achieved by that particular ingredient.
Chemical analysis
T2 (217.84 kcal) has less than half the value for calories compared to the control (521.10 kcal), largely due to the absence of deep frying and lower carbohydrate content.The addition of 30% of jackfruit seed flour increased the protein content to 25g (from 15g) and fiber content by six times (3.25g vs 0.54g).The product is an iron source in itself, producing iron as it contains high quantities of iron, recording an average of 5mg compared to the control’s 2mg.
Microbial analysis
The total bacterial count (5 times 104 CFU/g) well satisfied the ICMSF safety standards for ready-to-eat foods, which are no more than 105 CFU/g. The lack of yeast and mold development can be explained by the microwave drying of seeds and the low moisture content of the final product.
Antioxidant analysis
The formulation of T2 had retained considerable amounts of bioactive compounds (0.078 mg/g for phenolics and 0.50. The scavenging activity of the DPPH free radical was quite high at 71.85%. Though the processing temperatures might decrease the antioxidants, the final processed health snacks possess a significantly beneficial health component compared to health snacks processed in the normal manner.
Shelf life analysis
The product is microbiologically safe and sensorially acceptable for a period of 45 days.The airtight container was far superior to LDPE packaging. Airtight storage maintained more “crispness” and prevented sensory decline that took place around 30- 45 days.The increase in the bacterial load day by day within 45 days followed a typical trend for the baked snack but did not reach beyond the threshold of safety.
Cost analysis
The production cost of₹17 per 100g makes the product 15% cheaper compared with the standard price in commercial circles, which is around ₹20.The product evidences that the use of agricultural wastecan decrease end consumer costs while offering a better nutritional profile.
Conclusion
This study has effectively turned agricultural waste into a snack with added value by creating a nutritionally better and commercially viable snack using 30% jackfruit seed flour (T2). With a desirable crispness and a 15% cheaper production cost (₹17/100g) than the current commercial nutrisev, the improved formulation demonstrated outstanding sensory acceptance. The baked nutrisev was discovered to be a nutritional powerhouse, including significantly more protein (25g), six times more dietary fibre, and more than twice as much iron as the control, all while reducing its calorie count by more than half. Furthermore, when packed in airtight containers, the product maintained its excellent antioxidant qualities (DPPH scavenging capacity) and was both microbiologically safe and palatable for 45 days.This research, therefore, establishes the potential of jackfruit seed addition as a feasible approach for the development of affordable, shelf-stable, and functional snacks to cater to the demands of the modern health era.
Acknowledgement
The authors would like to express their heartfelt gratitude to Shrimathi Devkunvar Nanalal Bhatt Vaishnav College for Women, Chrompet, for providing the necessary facilities and support to carry out this review work. The authors also extend sincere thanks to the Department of Homescience for their constant guidance and encouragement throughout the preparation of this article.
Funding Sources
The author(s) received no financial support for the research, authorship, and/or publication of this article.
Conflict of Interest
The authors do not have any conflict of interest.
Data Availability Statement
This statement does not apply to this article.
Ethics Statement
This research did not involve human participants, animal subjects, or any material that requires ethical approval.
Informed Consent Statement
This study did not involve human participants, and therefore, informed consent was not required.
Clinical Trial Registration
This research does not involve any clinical trials.
Permission to reproduce material from other sources
Not Applicable
Author Contributions
Subaratinam R: Conceptualisation,Methodology, Validation, Formal analysis,Investigation
RajaPraveena S: Visualisation,Supervision
Thanveera Jasmin: Data curation, Writing-original draft preparation
Mahasrii Narayanan: Writing-review and Editing
References
- Rahman MM, Islam R, Khan MA. Valorisation of jackfruit seed flour in extrusion and bakery products. Curr Res Food Sci. 2024;7:102-110.doi:10.1007/s10068-024-01665-2
CrossRef - Silva J, Oliveira A, Santos L. Nutritional composition, physical characteristics, and functional properties of flours from different jackfruit (Artocarpusheterophyllus) components. Biochem J. 2025;9(4):4194-4205. DOI:33545/26174693.2025.v9.i4i.4194
CrossRef - Akubor PI, Badifu GIO. Chemical composition, functional properties and baking potential of African breadfruit kernel and wheat flour blends. Int J Food Sci Technol.2004;39:223-229
CrossRef - Amadi JE, Idu M, Donatus I. Proximate and mineral composition of jackfruit (Artocarpus heterophyllus) seeds. Journal of Applied Sciences and Environmental Management. 2018;22(10):1579-1582.
- Association of Official Analytical Chemists (AOAC). Official Methods of Analysis. 17th ed. Association of Official Analytical Chemists; 2002.
- Beleya J, Onyenorah E, Eke-Ejiofor J. The effect of processing methods on the functional and compositional properties of jackfruit seed flour. Int J Nutr Food Sci.2014;3:166-173. doi:10.11648/j.ijnfs.20140303.15
CrossRef - Burci LM, da Silva CB, Rondon JN. Acute and subacute (28 days) toxicity, hemolytic and cytotoxic effect of Artocarpus heterophyllus seed extracts. Toxicol Rep. doi:10.1016/j.toxrep.2018.02.006
CrossRef - Characterisation and sensorial evaluation of cereal bars with jackfruit. Acta Sci Technol.2011;33:81-85. doi:10.4025/actascitechnol. v33i1.6425
CrossRef - Comparing optimum barrier variables of aluminium and MPET foil laminates. J Appl Packag Res. 2018;10(2):45-56. doi:10.3390/polymers.
CrossRef - Gupta D. Antioxidant activity of jackfruit (Artocarpus heterophyllus) seed extracts. Research Journal of Pharmaceutical, Biological and Chemical Sciences. 2011;2(4):647-654.
- Hossain MA, Rahman SM, Anwar M. Influence of processing methods on phenolic content and antioxidant activity of jackfruit seeds. Journal of Food Biochemistry. 2020;44(6):e13189.
- Jangra S, Mishra R, Mishra A, Pandey S, Prakash R. Enhancing physicochemical and functional properties of wheat flour by dielectric barrier discharge plasma treatment. ACS Food Science & Technology. 2025;5(4):1459-1468. doi:1021/acsfoodscitech.4c01061.
CrossRef - Jain VK, Manoj, Shyam K. Cost estimation and economic analysis of food products. International Journal of Agricultural Sciences. 2018;10(2):35-39.
- Karnalkar IP, Mote GV, Sahoo AK. Nutrient rich baked sev. Journal of Pharmacognosy and Phytochemistry. 2018;7(3):1409-1413.
- Kuswandi B, Nurfawaidi A. Shelf-life estimation of food products. Food Research. 2017;1(1):1-7.
- Maurya S, Mogra R. Nutritional evaluation of jackfruit seed flour and its utilization in preparation of biscuit. International Journal of Science, Environment and Technology. 2016;5(3):1520-1528.
- Meethal SM, Kaur N, Singh J, Gat Y. Effect of addition of jackfruit seed flour on nutrimental, phytochemical and sensory properties of snack bar. Curr Res Nutr Food Sci. 2017;5(2):154-158. doi:10.12944/CRNFSJ.5.2.12
CrossRef - Agba TD, Yahaya-Akor NO, Kaur A, et al. Flour Functionality, Nutritional Composition, and In Vitro Protein Digestibility of Wheat Cookies Enriched with Decolourised Moringa oleifera Leaf Powder. Foods. 2024;13(11):1654. doi:3390/foods13111654
CrossRef - Pratama AA, Nur A, Hidayat T. Microbial quality assessment of ready-to-eat snacks. International Journal of Food Microbiology. 2019;305:108-115.
- Khule G, Ranvare A, Sing A. Nutritional and Sensory Evaluation of Gluten-Free Waffle Cone Prepared from Foxtail Millet and Khandsari Sugar. Eur J Nutr Food Saf. 2025;17(4):118-126. doi:10.9734/ejnfs/2025/v17i41684
CrossRef - Addo-Preko E, Amissah JGN, Adjei MYB. The relevance of the number of categories in the hedonic scale to the Ghanaian consumer in acceptance testing. Frontiers in Food Science and Technology. 2023;3. doi:3389/frfst.2023.1071216
CrossRef - Shivaranjini S, Hebbar HU, Raghavarao KSMS. Effect of extraction solvents on antioxidant and phytochemical properties of jackfruit seed powder. Food Chemistry. 2020;321:126688.
- Shrikanta A. Evaluation of total flavonoid content in jackfruit seed extracts. International Journal of Pharmaceutical Sciences Review and Research. 2013;20(1):115-118.
- Sosulski FW, Garratt MO, Slinkard AE. Functional properties of ten legume flours. Canadian Institute of Food Science and Technology Journal. 1976;9(2):66-69.
CrossRef - Vinothini K, Gopalakrishnan G, Padmashree N. Storage stability of baked snack foods. Journal of Food Science and Technology. 2015;52(7):4545-4551.
- Waghmare R, Memon N, Gat Y, Gandhi S, Kumar V, Panghal A. Jackfruit seed: an accompaniment to functional foods. Brazilian Journal of Food Technology/Brazilian Journal of Food Technology. 2019;22. doi:1590/1981-6723.20718
CrossRef - Wichchukit S, O’Mahony M. The 9-point hedonic scale and hedonic ranking in food science: some reappraisals and alternatives. Journal of the Science of Food and Agriculture. 2015;95(11):2167-2178.
CrossRef
Accepted on: 02-03-2026
Second Review by: Dr. Makhabbah Jamilatun
Final Approval by: Dr. Ali Elshafei